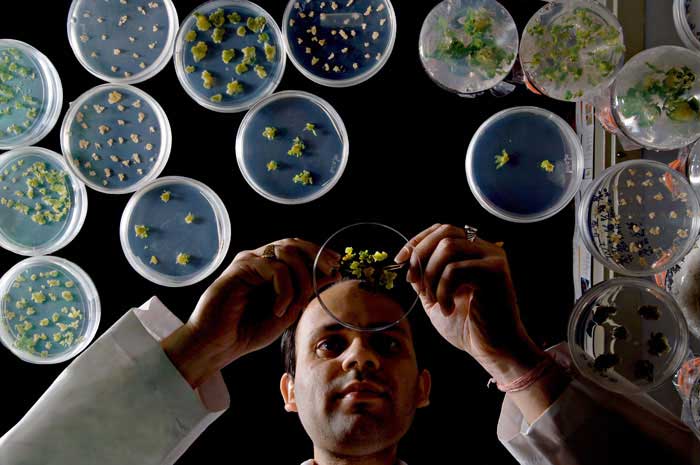

轉基因是人禍,不是自然災害,美國承認轉基因食品能害人
摘自淨空法師《淨土大經科注》第498集2013年11月2日講於香港
轉基因是人禍,不是自然災害,美國終於承認轉基因的食品能害人
“唯除大願。入生死界。為度群生。作師子吼。擐大甲胄。以宏誓功德而自莊嚴。”
“雖生五濁惡世。示現同彼。直至成佛。不受惡趣。生生之處。常識宿命。”
我們看念老的註解,前面一段說了,往生決定成佛,一生成佛。可是有些人他等不及,等成佛再度眾生,他說時間太長了,等不及。他有度眾生的大願,見到阿彌陀佛之後,他就想回到眾生的世界。他回來幹什麼?“為度群生”。眾生太苦了,現在我們看這個世界上眾生,真苦。迷惑顛倒,造作極重的罪業,他自己不知道,迷得太深了,迷得太重了。
中國古諺語有所謂,“宰相能看五十年”,這才能當宰相,能看到未來的五十年的演變。現在的人三年的眼光都沒有。他能看到未來三年嗎?可能明年的事情他都不知道,他怎麼能施政?現在有很多科學儀器幫助你,這些儀器帶來給你信息,有正面的、有負面的,從前是正面多過負面,負面少;現在是負面多過正面,不好的信息太多了,好的信息很少。
昨天我們看到一個報告,美國終於承認了轉基因的食品是能害人的。我聽說這一份資料好像兩年前就公佈了。雖公佈,知道的人不多,新聞媒體沒有轉播,現在播放出來了,對人體有嚴重的傷害。所以美國人自己不吃,美國人自己吃的糧食,他是正常方式耕種的,沒有轉基因;轉基因這些食品,糧食,蔬菜,水果,都是跟他們美國這農耕的土地距離很遠,距離很遠;那個都是賣給外國的,他們自己不吃的。特別是有疾病的人、生病的人,吃了會加重病況。現在就是飲食沒有安全感。特別是黃豆,人常吃,中國人常吃的豆腐、豆漿都是黃豆,如果從美國進口的黃豆,我們進口的多,每一年不知道進口多少,這怎麼辦?所以我們總是要找有機的。有機的是沒有農藥、沒有化肥;但是它要是轉基因,我們不知道,這都是災難。轉基因是人禍,不是自然災害,人為的。所以念佛人,真的,我們唯一的一條道路就是念佛求生淨土,這李老師說的;除此之外確實再想不出一條生路了。我們這一生總算很幸運,得人身,遇到佛法,遇到大乘,遇到淨土,太難得了!
“但有菩薩,發殊勝大願。願入生死界,教化有情。”
生死界就是六道。願意再回到六道裡面來教化眾生,能不能?能。方不方便?很方便。為什麼?他不用真身,他化身來。到極樂世界見到阿彌陀佛,得阿彌陀佛本願威神加持,剎那之間你的智慧、神通、道力跟法身菩薩幾乎平等,法身菩薩能幹的事情,你統統能幹得到,所以哪有障礙?!經上說的這幾句話,是佛特地說給我們聽的,用凡夫的思維能理解、容 易懂,這是佛的方便說。雖然是方便,也不離真實,他真有這個能力,教化有情。
“彼土菩薩親聞彌陀說法,即以所聞,轉教眾生。”
這個他有能力,他的報身聽佛說法,在佛的講堂沒有離開佛陀;他的化身,譬如說在我們娑婆世界六道輪迴裡頭,這是他的化身。他的真身在彌陀那裡聽的法,就傳給化身,化身佛就來教導我們。
“故所說法,親承如來。故亦如獅子之吼也。”
這用這個比喻,他把佛的話傳來了。
自古以來發動戰爭的人、參與戰爭的人都在地獄
“'擐'者,以身被掛鎧甲,名為擐。”
古時候打仗,這個將軍士兵都披上鎧甲,我們在圖畫裡面,看到古時候將軍,軍人,在戰爭時候披的這些鎧甲,我們看到,圖畫當中看到,到博物館裡面能夠看到,古時候留下來的這些遺物,確實有一些人用過的。
“冑者,鎧也。甲胄乃古代戰士被衣於身,以防矢石傷自肉體。”
這是防禦。那現在跟從前不一樣了,現在戰爭衝鋒用戰車、裝甲,同樣意思,用坦克衝鋒。將來有沒有戰爭?將來沒有戰爭了,為什麼?未來的戰爭是按鈕戰爭,不要衝鋒打仗了,不需要了,是飛彈、核子彈、原子彈。這一顆炸彈就毀掉一個城市,就能殺死幾百萬人。武器愈先進,時間愈短,用很少的人力,就能產生大面積的殺傷。
說到這個地方,我們就要想到,愛因斯坦附體那片光盤,那個光盤要大量流通,那不是假話,我們一定要把它看做可以相信的鬼話。鬼附身說的鬼話,可以相信,不能夠小看。他說他是地藏菩薩特別准許他到人間來附體,透出這個信息。他現在在地獄,無間地獄;地獄的名稱是核爆地獄。他發明核子彈後悔莫及,原來只是科學上研究,沒有想到以後用在戰爭,變成大殺傷力的武器。核爆地獄裡面的痛苦,是一切地獄之所不及,也就是所以地獄裡頭,他受的那個痛苦是第一。他說身體每一個細胞都在攝氏幾千度的高溫之下燒烤。他說這種武器很殘酷,是滅絕性的戰爭,連空氣裡面的細菌統統都死亡,沒有一個存在。空氣當中細菌,肉眼看不到的,核爆的時候全都死了。所以他說,他是發明的人,下達命令製造的人、執行製造的人、將來投彈的人,或者發射彈的人,統統都跟他一樣,都是核爆地獄。發射,以現在的科學技術,不需要用人工了,按鈕;按鈕的人,要到核爆地獄去受刑,非常可怕。他把這個信息透露之後,他還要到地獄去,他出不來,勸這些擁有核武國家,把核武最好銷毀,永遠不能用核武做戰爭,做武器。
凡是打仗、搞戰爭,自古以來發動戰爭的人、參與戰爭的人,都在地獄,到現在都沒出來,何苦來!為什麼人在世間要造這種罪業?佛經上講得很清楚,沒人相信。
治國平天下,唐太宗懺悔了,現在才知道,可以不必用戰爭這個手段,用老祖宗傳統文化可以達到,用佛教也可以達到。我們看到斯里蘭卡治國,完全用佛教,阿育王的兒子跟女兒把佛法傳到斯里蘭卡。那是佛滅度兩百多年,所以斯里蘭卡是佛教統治國家,二千三百年的歷史。我們不懂得佛教、不認識佛教,到斯里蘭卡住一二個月就明白了,佛教到底是什麼,佛教對人類有沒有好處,你會看到,你會聽到,你會接觸到。
......
希望妻子要學周朝的“三太”,要把兒女教成大聖大賢
這個地方一定要知道,佛菩薩沒有一定的身相,沒有,他“無我”。眾生有感,他能夠現“我”,隱現自在;眾生心裡想什麼身,他就現什麼身。眾生想佛,他現佛身;眾生想菩薩,他現菩薩身;眾生想羅漢,他就現羅漢身;眾生想天王、想上帝,他就現上帝身、現天王身。“隨眾生心,應所知量”。生生世世他現什麼身?幹些什麼事情,全知道。
“不昧本因。'示現同彼'。”
“'彼'者穢土眾生。”
如果示現跟眾生不一樣,就不能夠度眾生。一定要示現跟他同樣的身份,同樣的生活環境,眾生很容易接受。“'彼'者穢土眾生”,“穢土”就是六道輪迴,跟六道輪迴眾生完全相同,六道輪迴眾生迷了,這一生到這個世間來,過去生的事情忘掉了,記不住了。只有極少數他能夠記得前生的事情,佛在經上有說過、哪些人記得前生的事情?沒有坐胎的、如果母親懷孕他就來坐胎,他不記得,為什麼?那十個月胎胞裡太苦了,那個罪,受那個罪很苦,佛把它比做獄,地獄,叫胎獄,在胎裡面嬰兒感受的,就跟地獄受報差不多,非常苦。做母親的如果不懂,孩子受罪就更重。母親不知道胎教,任性,母親喝一杯熱水,小孩就像在八熱地獄'母親喝一杯冰水,就像在八寒地獄,他有感受。母親發脾氣,誰最難過?他最難過。所以他在胎胞裡頭隨著母親情緒變化。
也正因為這樁事實,所以中國古人知道重視胎教,不是沒有道理。胎教實在講,大學問!懂得胎教的母親是聖人,所以教出來的孩子也是聖人。
現在社會麻煩,女人要跟男人爭權,女權。要爭著做國家領導人,男人能幹,女人也能幹,沒錯:自己幹得不錯,下一代沒有了。中國古時候,我們看中國古時候教學,教女比教子更重視。兒子差一點沒關係,女兒可不能差,女兒要全心全力教她,為什麼?她的權比男人大,這個權是上天賦給她的。現在很多人把上天賦給她的,她不要,她要她自己名聞利養,不輸給男人,她的成就就一代。如果她要懂得上天給她的權她掌握住,上天給她的權是什麼?相夫教子。你照顧你的先生、小孩教好,教小孩是第一個使命,把小孩教成大聖大賢,不必自己去做領導,讓你的兒孫當領導。
中國古時候有典範,周家出三個聖人,文王、武王、周公,大聖人,母親教的。周家有三個婦女,文王的祖母太姜;文王自己的妻子太任;武王是文王的兒子,周公是武王的弟弟,也是文王兒子,武王的夫人太姒。太姜、太任、太姒,所以“太太”名詞從這來的。“太太”是什麼意思?聖人的媽媽,她的兒女都是聖人。所以中國人稱自己的妻子為“太太”,就是希望妻子要學三太,要把兒女教成大聖大賢,那個對國家對社會,對整個人類作出偉大的貢獻,是這個意思。不是叫你去當董事長,不是!不是叫你幹這個的。你的那個董事長領導人甚麼,要給你兒子孫子去幹去,不是你自己幹的,所以中國教育教人真正明理、真正懂得,自我會做出犧牲奉獻。
女人能夠做領導,做國家元首,那是聖人,可惜她做了,她沒有教她兒子做。她要能教她兒子做,兒子會做得更好,為什麼?她自己做上之後,她的心就不清淨了;她教給她兒子做,她心清淨的,她是她兒子的老師,她是她兒子的顧問,兒子哪個地方做錯了之後,她就會去告訴他、去糾正他,所以他成為聖王、成為明君。現在這些話沒人講了,講了也沒人聽。
積大功、累大德,果報在天上。文王,武王,周公,他們現在在哪裡?欲沒有斷在欲界天。欲界六層天,他們累積的功德不相同,累積的功德愈高,生天也愈高。天,確實是人類非常嚮往的地方。看就是忉利天,中國人都嚮往,忉利天的天主玉皇大帝,中國人稱作“玉皇大帝”。天上一天,人間一百年,天人看我們這些人真可憐,朝生暮死,壽命這麼短。像我們看蜉蝣,水上走來走去的蜉蝣,它的壽命只有幾個小時,不到二十四小時,它的一生。忉利天看我們就是蜉蝣,壽命太短了。孔老夫子在忉利天,我們相信文武周公至少也在忉利天,可能在忉利天之上,在夜摩天、在兜率天。
人間時間雖然不長,可以積功累德,要多做好事,斷惡修善,積功累德,最聰明的人。十幾年前黃念祖老居士在世,他過世之後,那時候我還常到北京,他的學生來告訴我,老居士沒有當面給我講過,對他的學生講,說淨空法師如果要不往生極樂世界,來生的福報不得了、不得了。他們把這個話傳給我。我要不要來生福報?如果要就上大當了。我們一定要懂得,四禪天王、摩酰首羅天王,讓位給我我也不要,我知道那沒出六道輪迴,那就不是好事情。摩酰首羅天王是娑婆世界的最高的天王,他統治三千大千世界;大梵天王只統治初禪天,比六道高,六道是欲界,比欲界高。欲界裡面最高的就是波旬,波旬的第六天的天王,欲界第六天,他化自在天。不能幹,決定不能被誘惑!被誘惑你就上大當了,一定到極樂世界!到極樂世界親近阿彌陀佛、觀音、勢至、文殊、普賢,這天天見面,跟這些人在一起好,道業天天增長,煩惱不知不覺自然就斷乾淨了,一定要認識清楚。
世間第一等的大事是教學
天上天王都不想幹,人間名聞利養還會著嗎?自然不會了。人間這算什麼?遇到好的事情要幹,不管事情成不成就,你只發心你的功德就圓滿了。
世間第一等的大事是什麼?佛選擇的,菩薩選擇的,他選擇什麼?教學,你就曉得教學大,大過做天王。
周公從政,輔助成王,治國平天下,做得好。孔子一生最羨慕的,周公,他就想當第二個周公,所以周遊列國。周遊列國干什麼?希望有一個國王能夠任用他,請他去做宰相,他就能展示他的抱負,把這個國家治好,讓一國人信服。但是周遊列國十幾年沒人用他,六十八歲,老了,到退休年齡了。七十歲退休,古時候。沒指望了,回老家。回老家教學,七十三歲過世,只教了五年。你看,六八、六九、七十、七一、七二,七十三走的,教學的時間不長,被後人尊為“聖人”,“至聖先師,萬世師表”。
如果孔子當年要知道這個,何必去周遊列國,他是三十歲就學有成了,“三十而立”,跟釋迦摩尼佛一樣。三十歲就開始教學,要教到七十三歲過世,你說他的功德多大!所以釋迦摩尼佛比他聰明,釋迦摩尼佛是太子,現成的國王不做,他去教學,七十九歲過世,講經教學四十九年,這是做例子給我們看。
我們要看清楚,教學是多麼自在、多麼快樂!教學不受任何拘束,沒有壓力,這個人生真正是方老師所說的“人生最高的享受”,比帝王高,;比帝王幸福,比帝王快樂。帝王有的,佛不缺,孔子也不缺。你的學生多了,有成就了,自然天天有人送供養,跟當皇帝差不多,為什麼沒有看到、為什麼沒有想到?
可以做帝王師,不做帝王。你來請教,我可以教你怎樣做個好的帝王;做一個真正對國家民族、對世界人類有真正貢獻的國王,讓人家世世代代想念你。我能夠教你,自己不干。自己要到極樂世界,到阿彌陀佛那裡,我才真正學圓滿了,真正畢業了
沒有留言:
張貼留言